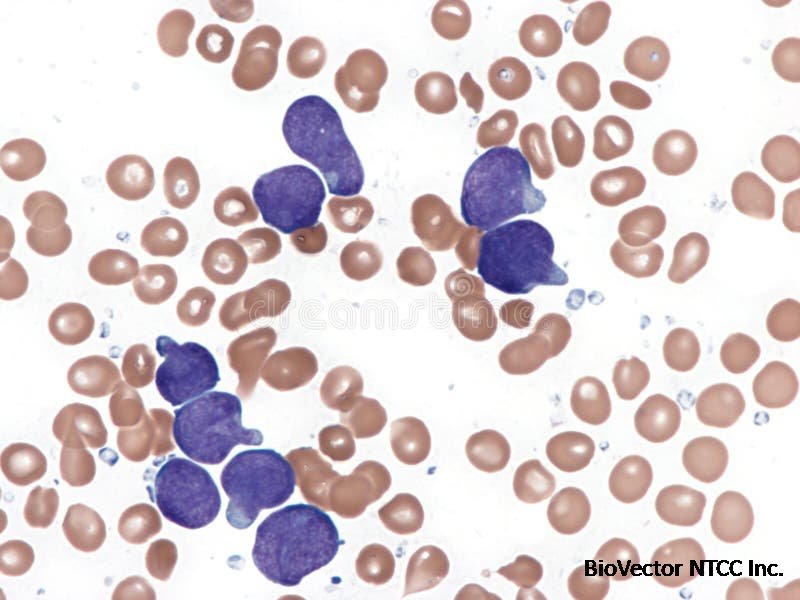
T-cell Acute Lymphoid Leukemia. Bone Marrow. Stock Photo - Image of  lymphocytes, lymphoblastic:349353254

MOLT-16 NTCC®人T细胞急性淋巴细胞白血病细胞株T-cell acute lymphoblastic leukemia (T-ALL) cell line-BioVector NTCC典型培养物保藏中心
- 价 格:¥99860
- 货 号:NTCC®MOLT-16
- 产 地:北京
- BioVector NTCC典型培养物保藏中心
- 联系人:Dr.Xu, Biovector NTCC Inc.
电话:400-800-2947 工作微信:1843439339 (QQ同号)
邮件:Biovector@163.com
手机:18901268599
地址:北京
- 已注册
The NTCC® MOLT-16 cell line is a human cell line used as a model for T-cell acute lymphoblastic leukemia (T-ALL), a highly aggressive type of blood cancer. It was established from the peripheral blood of a 5-year-old girl who had a relapse of T-ALL.
Key Characteristics

Origin: The cell line was derived in 1984 and is a sister cell line to MOLT-17.
Cell Type: It is a T-lymphoblastoid cell line, meaning it is a type of white blood cell (T-cell) that has become cancerous and has immature characteristics (lymphoblast).
Growth: The cells grow in suspension, which is typical for blood cancer cell lines.
Genetic Profile:
It has a near-diploid karyotype, but with several complex chromosomal translocations.
A significant genetic feature is a translocation involving chromosomes 8 and 14, specifically t(8;14)(q24;q11). This translocation brings the MYC oncogene on chromosome 8 into close proximity with the T-cell receptor alpha chain (TCR-alpha) gene on chromosome 14, leading to the overexpression of the MYC oncogene, which is a known driver of cancer.
It expresses key T-cell markers such as CD2, CD3, CD5, CD7, and the T-cell receptor.
Drug Sensitivity: The MOLT-16 cell line has been profiled for its sensitivity to various drugs, and this data is used in drug screening projects.
Research Applications
The MOLT-16 cell line is a valuable resource for oncology research, especially in the study of pediatric T-ALL. Its main applications include:
Disease Modeling: It serves as a representative model for T-cell acute lymphoblastic leukemia, allowing researchers to study the disease's progression and unique biological properties.
Genetic and Molecular Studies: The cell line is used to investigate the role of specific genetic mutations and translocations (like the t(8;14) translocation) in the development and maintenance of T-ALL.
Drug Discovery and Screening: Due to its established genetic and drug-response profiles, it is a key tool for screening new therapeutic agents and understanding the mechanisms of drug resistance.

NTCC® MOLT-16 细胞系是一种人类细胞系,被用作**T 细胞急性淋巴细胞白血病(T-ALL)**的模型。T-ALL 是一种侵袭性极强的血液癌症。该细胞系是从一名患有 T-ALL 复发的5岁女孩的外周血中建立的。
主要特点
来源: 该细胞系于1984年建立,是 MOLT-17 细胞系的姊妹系。
细胞类型: 它是 T 淋巴母细胞样细胞系,意味着它是一种已癌变的白细胞(T 细胞),并具有未成熟的特征(淋巴母细胞)。
生长方式: 这些细胞在悬浮培养中生长,这是血癌细胞系的典型特征。
遗传学特征:
它具有近二倍体核型,但存在多个复杂的染色体易位。
一个重要的遗传特征是涉及8号和14号染色体的易位,即 t(8;14)(q24;q11)。该易位将8号染色体上的 MYC 致癌基因与14号染色体上的 T 细胞受体α链(TCR-alpha)基因紧密相连,导致 MYC 致癌基因的过表达,而 MYC 基因是已知的癌症驱动基因。
它表达关键的 T 细胞标记物,如 CD2、CD3、CD5、CD7 和 T 细胞受体。
药物敏感性: MOLT-16 细胞系已针对多种药物的敏感性进行了分析,这些数据被用于药物筛选项目。
研究应用
MOLT-16 细胞系是肿瘤学研究,特别是儿童 T-ALL 研究的宝贵资源。其主要应用包括:
疾病建模: 它作为 T 细胞急性淋巴细胞白血病的一个代表性模型,使研究人员能够研究该疾病的进展和独特的生物学特性。
遗传和分子研究: 该细胞系被用于探究特定基因突变和易位(如 t(8;14) 易位)在 T-ALL 发生和维持中的作用。
药物发现与筛选: 由于其已建立的遗传和药物反应图谱,它是筛选新疗法和理解耐药机制的关键工具
BioVector NTCC质粒载体菌种细胞蛋白抗体基因保藏中心
BioVector NTCC Inc.
TEL: 400-800-2947, 189-0126-8599
E-mail: biovector@163.com
- 公告/新闻




